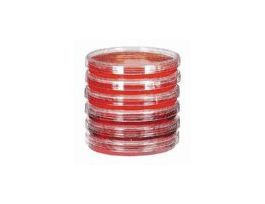
Sterile Petri Dishes; 60 mm dia x 15 mm H; 500/box

Need Help?
800-229-7252
Lab Equipment
-
Sterile Bi-Plate Petri Dish w/ Frosted Area, double bagged w/ labels; 825/pkBI93D-102CPEW-34552-05-CS -
Sterile Petri Dish, 100 x 15 mm, double bagged, traceability labels; 825/pkBP93B-102CPEW-34551-83-CS -
Sterile Petri Dish, 150 x 15 mm, double bagged, traceability labels; 176/pkBP143-06CPEW-34551-80-CS -
-
-
-
-